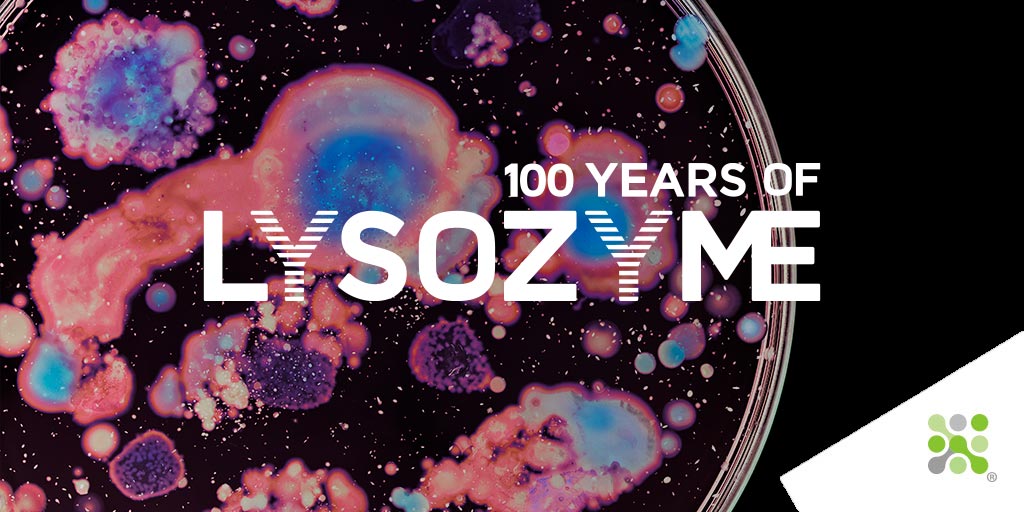
From 3p for tears to £3 for #Picasso s, this week we release the final instalment of ‘A beginning for #Lysozyme’, part of our celebration of #100yearsofLysozyme. Learn more here: bit.ly/3q7lOMV
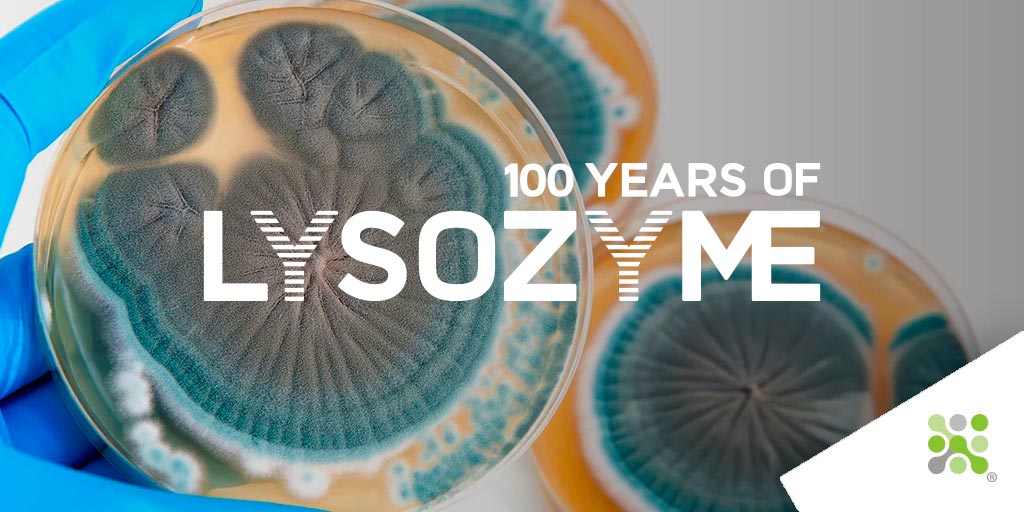
#Pencillin arrives on Italian shores for the first time in #1943. It is only another 4 years until our founder Dr. Rodolfo Ferrari began its Italian manufacture, paving the way for our 70 year long story with #Lysozyme. Learn more here: bit.ly/3ODZvJJ

Bioseutica
@bioseutica
The #1st choice for #food, #feed and #pharma #ingredients: #nootropics #lysozyme #otrf #diagnostics #foodsafety #cleanlabel #microbiome #AMR
ID: 1649943030
https://bioseutica.com 06-08-2013 10:01:23
2,2K Tweet
1,1K Takipçi
966 Takip Edilen


bit.ly/3LOB2jl It’s 100years since news of #Lysozyme’s discovery reached the The Royal Society! To celebrate we will be hosting a #conference: 29-30 Oct, details #TBA! Let us take u on the journey of a #100years story; the 1st installment of our series is live!#SaveTheDate






For that reason AMR Insights has developed: 1) overview recent news & publications on #AMR & animal health: amr-insights.eu/category/news/… 2) landing page for animal health workers: amr-insights.eu/focal-areas/he… #AMRinsights #AntimicrobialResistance







🚀 We are excited to announce our acquisition of 2 wound-healing cell therapy assets from Smith+Nephew 🩺 These #autologous and #allogenic therapies will support our mission of improving the lives of #chronicwound patients 👉bwnews.pr/3N9NGtw Follow our founder Prasenjeet Dutta





There's still time to show your support by voting for us in the Venturelab top 100 startup competition 📈 Click here 👉startup.ch/Healiva #TOP100SSU #startups #competition #woundcare

Bioseutica is looking for a Customer Service Manager to join us in Zeewolde, The Netherlands. Read more on our website bit.ly/3QCighM or apply on LinkedIn. bit.ly/3WoOUFb #job #jobopportunities #jobsearch